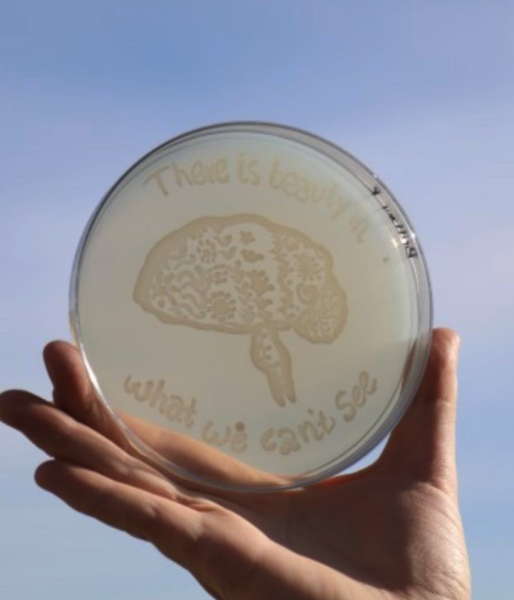

img-7062.jpg

70b0b2b4-a46a-457b-af16-9c66c07585cb.jpeg

183cb1ab-b1dd-4140-b66c-0578f26164bd.jpeg

haynie.jpg

lizgrad2-1-of-1.jpg

43c247a7-98a9-4f7f-8c81-a997b466c1d1.jpeg

img-7938.jpg

20210415-162143-0001.png

Screen Shot 2021-04-22 at 3.01.28 PM.png

Screen Shot 2021-04-22 at 10.57.29 AM.png

Screen Shot 2021-04-22 at 10.57.19 AM.png

Screen Shot 2021-04-22 at 10.57.12 AM.png

Screen Shot 2021-04-22 at 10.57.02 AM.png

Screen Shot 2021-04-22 at 10.54.22 AM.png

Screen Shot 2021-04-22 at 8.38.39 AM.png

db5affad-b26d-4af7-84ea-2448124cedae.jpeg

img-3870.jpg

70bb4505-df74-4726-8470-fe560319c3a6.jpeg

Screen Shot 2021-04-21 at 1.14.14 PM.png

Screen Shot 2021-04-21 at 1.04.56 PM.png

Screen Shot 2021-04-21 at 1.04.06 PM.png

Screen Shot 2021-04-21 at 1.03.02 PM.png

Screen Shot 2021-04-21 at 1.02.05 PM.png

Screen Shot 2021-04-21 at 9.17.32 AM.png
anna everett.JPG

Lance graduation.jpg
Screen Shot 2021-04-07 at 12.47.35 PM.png

Screen Shot 2021-04-07 at 12.47.06 PM.png

20210408_194016.jpg

20210408_193613.jpg

20210408_191339.jpg

unnamed.jpeg
BYU_2005-06 134
2005-06 134
2005-06 Zachary Aanderud Lab
Alison Barrett works in Dr Zachary Aanderud's lab to test wastewater to quantify the concentration of COVID-19 specific RNA by taking samples, inactivating the virus, centrifuging it and then filtering the liquid.
May 12, 2020
Photo by Jaren Wilkey/BYU
© BYU PHOTO 2020
All Rights Reserved
photo@byu.edu (801)422-7322
Jaren Wilkey/BYU
BYU_2005-06 023
2005-06 023
2005-06 Zachary Aanderud Lab
Senior BYU Microbiology student Kevin Torgerson demonstrates the filtering process in Dr Aanderud's lab. Researchers in Dr Zachary Aanderud's lab test wastewater to quantify the concentration of COVID-19 specific RNA by taking samples, inactivating the virus, centrifuging it and then filtering the liquid.
May 12, 2020
Photo by Jaren Wilkey/BYU
© BYU PHOTO 2020
All Rights Reserved
photo@byu.edu (801)422-7322
Jaren Wilkey/BYU

2103-55 113.jpg
2103-55 113
2103-55 BYU PCR Lab
Mary Davis and the BYU PCR Lab in the Student Health Center runs COVID tests on campus.
March 09, 2021
Photo by Jaren Wilkey
© BYU PHOTO 2021
All Rights Reserved
photo@byu.edu (801)422-7322
Jaren Wilkey
BYU_2007-21 067
2009-19 632
2009-19 Dragonfly Research
Associate Professor Seth Bybee and Assistant Professor Paul Frandsen with student Alyssa Pike in the field researching Dragonflies.
September 4, 2020
Photography by Nate Edwards/BYU
© BYU PHOTO 2020
All Rights Reserved
photo@byu.edu (801)422-7322
Nate Edwards

2103-55 189.jpg
2103-55 189
2103-55 BYU PCR Lab
Mary Davis and the BYU PCR Lab in the Student Health Center runs COVID tests on campus.
March 09, 2021
Photo by Jaren Wilkey
© BYU PHOTO 2021
All Rights Reserved
photo@byu.edu (801)422-7322
Jaren Wilkey

IMG_4098 2 (2).jpg

DSC01342.jpg

DSC01872.jpg

DSC04196 (1).jpg

DSC02046.jpg